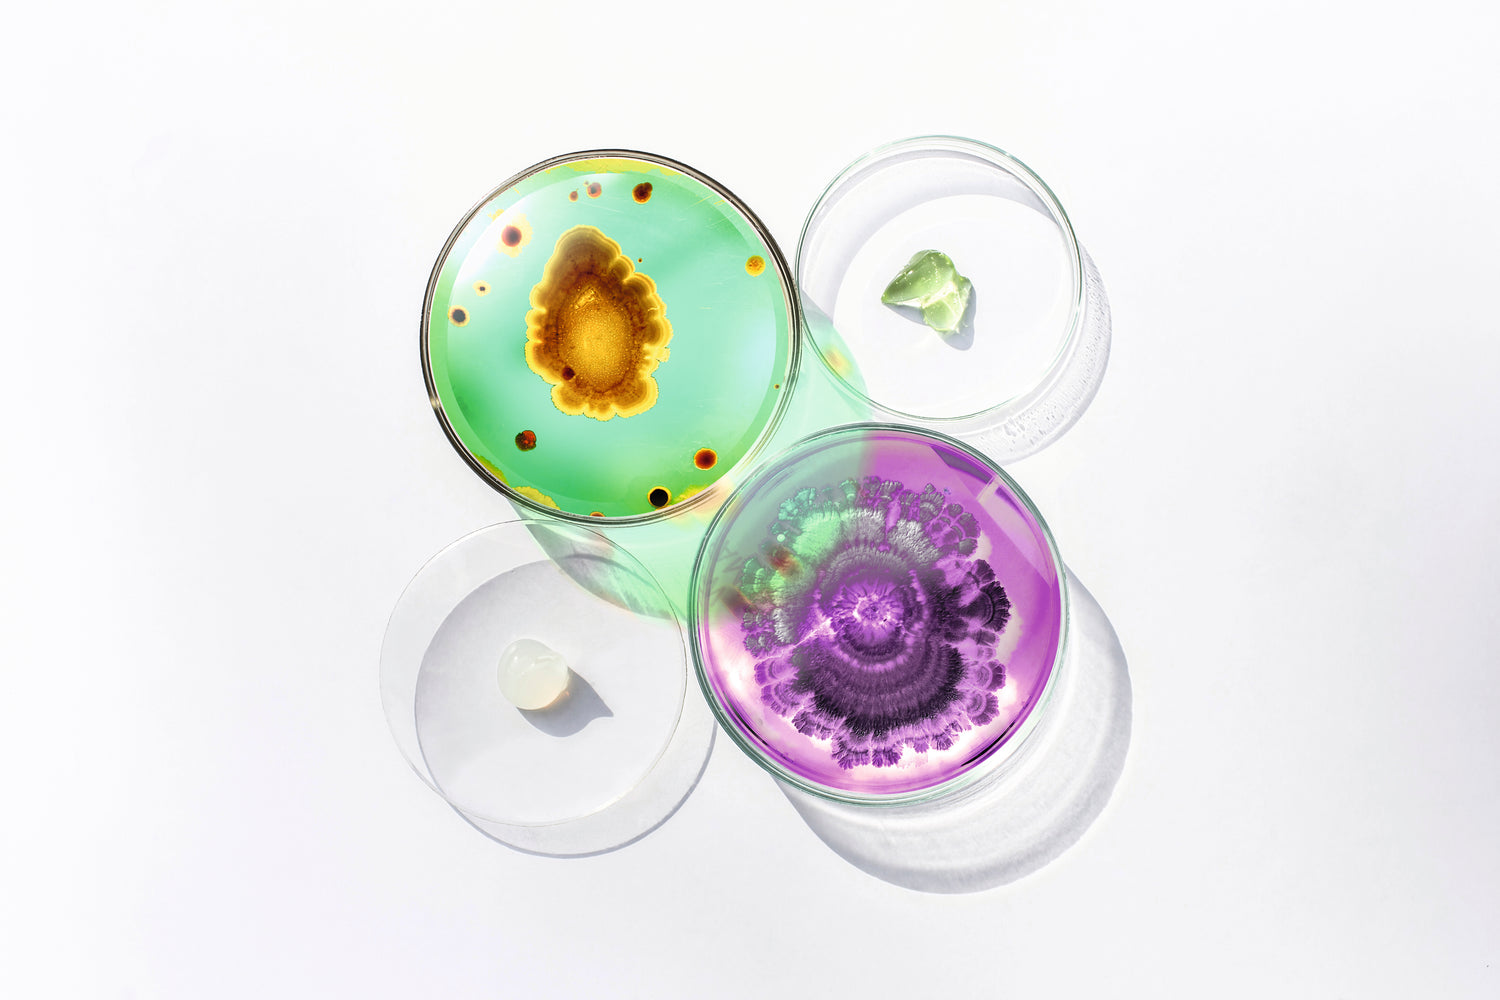

回歸原始重塑新肌
微生物群護膚
我們的微生物就像有生命的盔甲一樣,能夠保護我們免受病原體的侵襲,並強化皮膚屏障功能。
Esse致力研究讓皮膚重歸「原始」狀態的技術,希望利用益生菌和綠色化學來恢復皮膚與生俱來的微生物組。
可摺疊的內容
甚麼是微生物?
微生物是一種單細胞的微小有機生物。這包括了細菌、病毒、酵母和古細菌等等。 你身體內以及身體表面的全部微生物合起來統稱為你的微生物組。 「你體內的每個人體細胞最少有 10種微生物。」----人類微生物研究計劃 我們每一個人都是個複雜的生態系統 ——一個混合了人體細胞和微生物的和諧組合。
人類微生物研究計劃於 2013 年總結道:「微生物比人類提供更多人類生存必不可缺的基因。」 微生物對你的健康非常重要,它們不僅出現在你的腸道裡,還會在肺部、口腔、耳朵、頭髪和我們 最關注的 - 皮膚上出現。
這些新發現改變了我們對皮膚的瞭解。 所有旨在延緩衰老的產品都應該把你的常駐微生物納入考慮 範圍中。微生物是伴隨你和你的祖先幾千年的伙伴,而你正需要它們來提升你的皮膚的健康。
研究清楚顯示,微生物的高度多樣性與良好的健康相關。相同的研究發現,美國人已經失去了高達 25 % 的微生物多樣性。這對我們大部份人來說也是一樣。 你需要保育肌膚上和肌膚裡面的生態系 統,而現代的生活模式(特別是當我們使用了抗生素之後)其實對微生物多樣性有顯著的影響。
Esse 視皮膚為一個生態系統。並就著對肌膚微生物組的影響,對產品中的每一種成份進行仔細考量 。
會損害微生物組的因素:
> 抗生素能永久地改變你的微生物組。
> 經剖腹出生的嬰兒可能有較弱的免疫系統。
> 在無菌的環境成長及缺乏與大自然接觸。
> 氯化水(飲用水和游泳池水)。
> 高酸鹼值的肥皂
> 加工飲食 — 高度防腐及高糖食物
> 主流的化妝品成分
Esse致力維持微生物多樣性和促進有益微生物的繁殖,實行以量擊退病原微生物。
Esse以活性益生菌、益生菌提取物和益生元來為肌膚補充營養。
Ready for Summer
How to Pick?
Sensitive 敏感系列
應用於反應性肌膚的益生菌
EsseSensitive 敏感系列的產品結合了先進的益生菌(BIOME+)技術及溫和的有機成分,可恢復皮膚屏障功能,減緩肌膚的敏感狀況。通過培養肌膚降低自身的反應性,EsseSensitive敏感系列能減低肌膚出現過敏反應的機會。隨著您的皮膚恢復正常,您將能夠結合使用其他 Esse™ 系列來解決老化問題。
Plus 高端系列
頂級抗衰老益生菌
源於益生菌及科研的Esse™ Plus 高端系列,體現了品牌致力提供最先進益生菌抗衰老護膚品的理念。全方位活性益生菌平衡精華液作為系列的重點產品,運用活性益生菌來調節、塑造肌膚的生態系統,每滴精華液含 100 萬活性益生菌,這全球首創的技術,將帶來無可比擬的護膚享受。
Esse™ Plus 高端系列中的所有產品均含有高水平的益生菌和革命性的抗衰老護膚活性成分,為肌膚帶來顯著的功效。
Clarifying 淨痘系列
應用於問題肌膚的生物技術
現今,超過 80% 的青少年和大約 4% 的成年人患有暗瘡。從前當人們過著傳統農村生活之時,暗瘡非常罕見,甚至是不存在的。淨痘系列為這種炎症性皮膚狀況提供了另一種解決方法:將傳統的活性成分(如水楊酸)與微生物組技術相結合,以重新建立健康、平衡的肌膚。淨痘系列的產品透過大幅減低皮膚屏障的破損,從而減少皮膚的炎症負荷。
產品含有針對性成分,可吸收雜質、調節皮脂分泌、減少細菌過度增長及鎮靜發炎的皮膚。
Core 基本系列
我們的日用益生菌產品
EsseCore基本系列產品蘊含革命性的益生菌技術。這些配方裡所包含的益生元和益生菌提取物具關鍵作用;能自動為皮膚上的有益微生物提供營養。平衡的皮膚微生物群能改善屏障功能,有助鎖住水分並防止毒素進入,繼而減少亞臨床炎症並有效地延緩衰老。
Best Sellers




